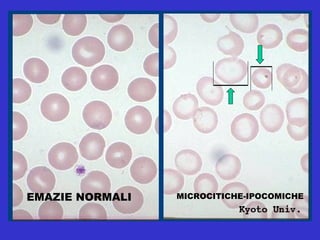
EMAZIE NORMALI MICROCITICHE-IPOCOMICHE
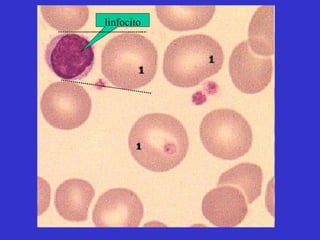
linfocito
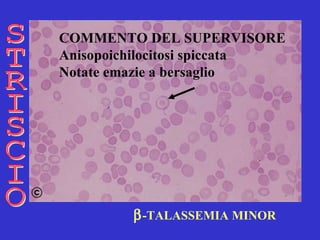
 -TALASSEMIA MINOR STRISCIO COMMENTO DEL SUPERVISORE Anisopoichilocitosi spiccata   Notate emazie a bersaglio
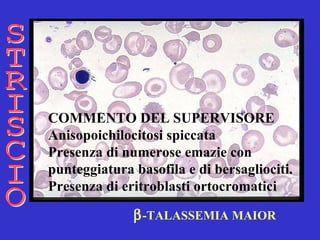
 -TALASSEMIA MAIOR STRISCIO COMMENTO DEL SUPERVISORE Anisopoichilocitosi spiccata   Presenza di numerose emazie con  punteggiatura basofila e di bersagliociti.  Presenza di eritroblasti ortocromatici
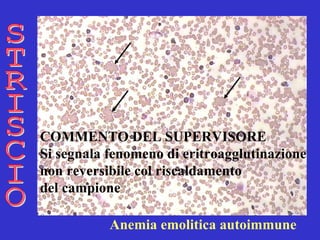
STRISCIO COMMENTO DEL SUPERVISORE Si segnala fenomeno di eritroagglutinazione  non reversibile col riscaldamento  del campione   Anemia emolitica autoimmune
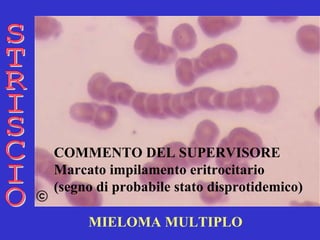
MIELOMA MULTIPLO STRISCIO COMMENTO DEL SUPERVISORE Marcato impilamento eritrocitario (segno di probabile stato disprotidemico)

Il documento offre una panoramica dettagliata sulle anemie, includendo definizioni, classificazioni e modalità diagnostiche. Viene sottolineata l'importanza dell'esame emocromocitometrico e dei parametri eritrocitari per la diagnosi e il monitoraggio delle anemie, che sono condizioni patologiche presenti in molte malattie. Il documento discute anche la complessità della diagnosi dell'anemia in relazione a vari fattori e meccanismi patogenetici.